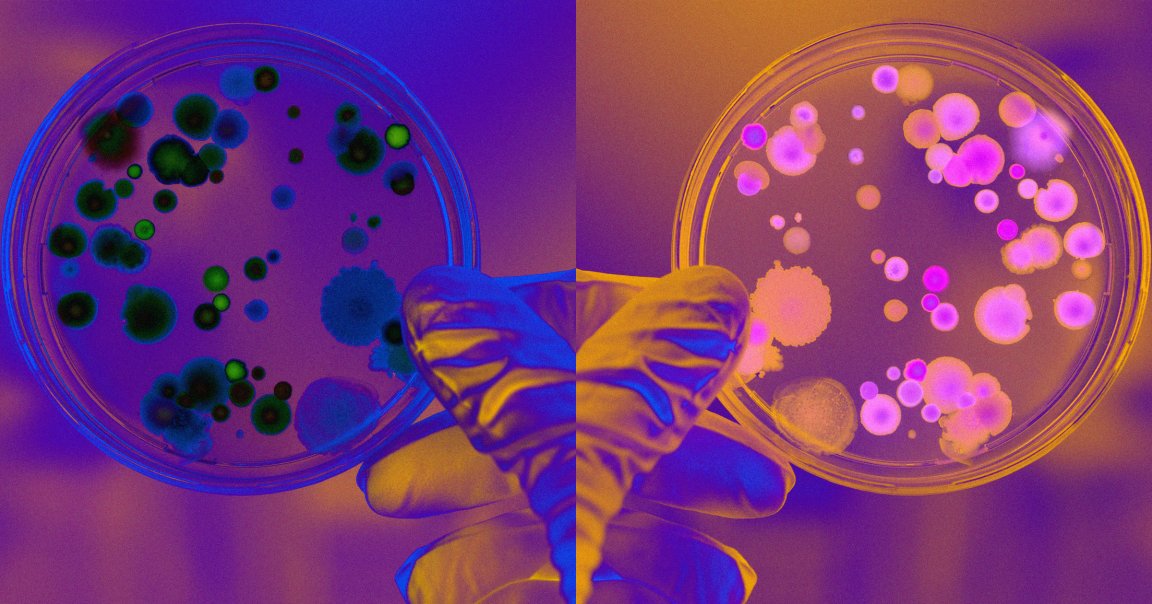

Scientists have warned that research into “mirror life” organisms — hypothetical life forms made up of molecules that perfectly mirror those found in regular life — should be stopped.
Theoretically, it’s a cool idea. But some scientists are worried that these life forms, if they’re ever realized, could turn into a major risk for the world around us by turning into an unstoppable force that spreads without limits, overrunning and choking out natural organisms in its path.
As Nature reported last year, mirror organisms could pose risks to pretty much all existing life if unleashed. They’d be like the ultimate invasive species, with no natural predators, and capable of evading pathogen detection systems found in nature because they’re just so radically different.
In a 300-page technical report published by Stanford University in December, scientists laid out the risks posed by mirror life, from pandemics to crop losses and ecosystem collapse.
“The consequences could be globally disastrous,” coauthor Jack Szostak, a Nobel-prize-winning chemist at the University of Chicago, told The New York Times at the time.
Other scientists, however, say these risks are completely overblown, as Nature noted in a follow-up article this week, pointing out we’re likely still many years away from synthesizing larger mirror molecules, let alone entire organisms. And even if it did come to exist, and it did escape the lab, some experts think that nature would have ways to defend itself.
The disagreement has shaken the scientific community. This week, researchers convened in Manchester, UK, to debate whether research into mirror life should be allowed or halted.
Proponents of the research argue that “reverse chirality“ molecules could be used to create promising new drugs, as they’re not as readily recognized by the human body’s enzymes and immune system. At the same time, such a resistance could be potentially dangerous, allowing drugs to proliferate uncontrollably in the body, according to Nature.
Biochemist and pharmaceutical founder Sven Klussmann told the publication that it’s worth considering the risks.
“But we should not panic yet, and we should not restrict research too early,” he said.
However, not everybody agrees. A group of scientists with the nonprofit Mirror Biology Dialogues Fund has sponsored meetings to discuss the dangers of creating mirror-image cells, with some members choosing to drop the research entirely.
So far, scientists have found ways to produce short strands of mirror-image DNA, RNA, and amino acids. But larger and more complex molecules remain a challenge.
Ting Zhu, a molecular biologist at Westlake University in Hangzhou, China, argued in a Nature opinion piece that the risks are exaggerated.
“Amid the race to take action, it is important not to let concerns and anxieties obscure our judgement of the underlying unknowns,” he wrote.
“It is crucial to distinguish mirror-image molecular biology from hypothetical scenarios in the distant future, such as the creation of mirror-image organisms,” the piece reads.
Zhu told Nature that synthesizing a mirror-image ribosome, a particle that contains RNA and information to build proteins inside living cells, “could dramatically accelerate pharmaceutical discovery by enabling high-throughput production of mirror-image peptides.”
Other researchers agree that the dangers are overblown.
University of Alberta chemical biologist Ratmir Derda told Nature that mirror life is already “here on Earth,” pointing out that the human body has already evolved to detect mirror-image sugars.
“They’re being used by certain life forms,” she said. “It would be unfair to say that we’re completely unprepared.”
In a commentary piece for Science, organic chemist and drug discovery expert Derek Lowe urged caution.
“For what it’s worth I think that we are sufficiently far from producing any actual organisms that I am not worried about this research,” he wrote. “But I think it is prudent to think about what could eventually happen, and perhaps set some tripwires for the future.”
More on mirror life: Scientists Horrified by “Mirror Life” That Could Wipe Out Biology As We Know It